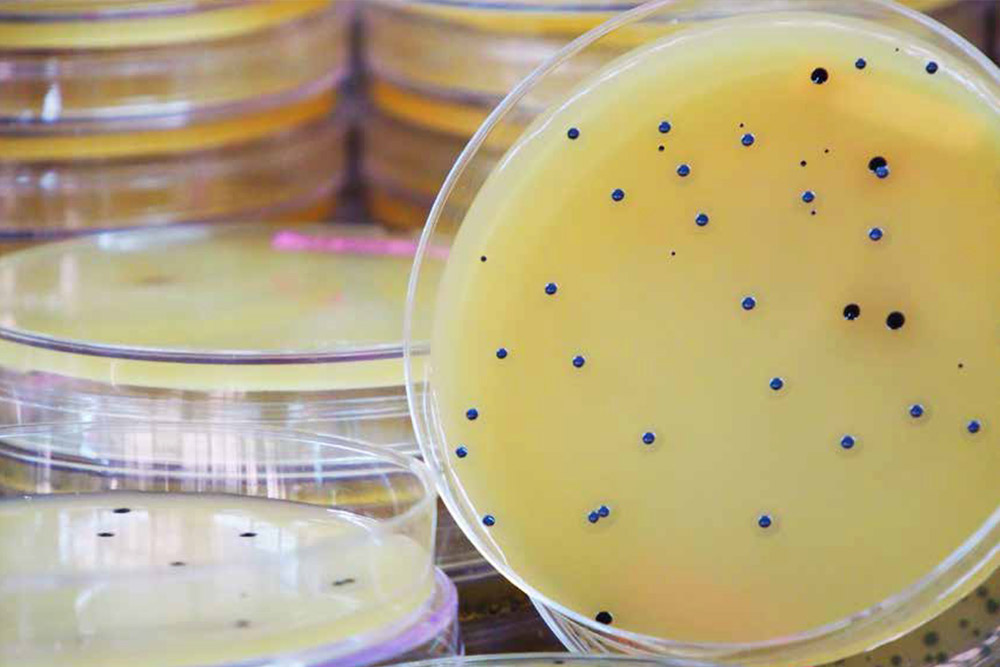
Webinar image

Webinaires :
Sciences de la vie
Webinaires sur les sciences de la vie, de l'immunothérapie, la thérapie génique, les vaccins et la culture cellulaire aux solutions de flux de travail et d'intégrité des données pour votre laboratoire.
En savoir plus
Webinaires :
Sciences de la vie
Webinaires sur les sciences de la vie, de l'immunothérapie, la thérapie génique, les vaccins et la culture cellulaire aux solutions de flux de travail et d'intégrité des données pour votre laboratoire.
En savoir plusA venir
S'inscrire aux prochains webinaires
Lorem Ipsum
Upcoming Webinars
Sciences de la vie
Tous les webinaires

Corning : Systèmes X-SERIES™ pour un traitement cellulaire simple et efficace
Corning et le canal Fisher Scientific vous accompagnent dans vos protocoles d’immunothérapie cellulaire.
Voir le replay
Thermo Scientific : La nouvelle génération d'oligonucléotides thérapeutiques
La thérapie génique et les vaccins à ARNm grâce aux progrès liés aux nanoparticules lipidiques et aux vecteurs viraux ont augmenté le besoin d'analyse.
Voir le replay
Solutions de filtration R&D Pall Pharma
Solutions innovantes pour les protocoles de recherche en Sciences de la vie.
Voir le replay
Binder : Optimisez votre protocole de culture cellulaire
Des solutions pour la culture, le passage et la décontamination.
Voir le replay
Eppendorf : Plastiques intelligents - Améliorer la fiabilité et la reproductibilité de la qPCR
Comment produire des données plus fiables en qPCR en utilisant des plastiques intelligents?
Voir le replay
Corning : Culture cellulaire et développement de vaccins
Solutions Corning pour la culture cellulaire et la fabrication de vaccins.
Voir le replay
Merck : L’art de la préparation des échantillons pour l’analyse instrumentale
Découvrez comment Merck Millipore peut améliorer votre préparation des échantillons grâce à des consignes faciles.
Voir le replay
Cytiva : Obtenez des résultats reproductibles en culture cellulaire
En culture cellulaire, des résultats reproductibles sont la clé du succès. Nous allons revenir sur la qualité des produits utilisés, leur expédition, leur manipulation et leur stockage, ainsi que sur la manipulation et l’expérimentation cellulaires.
Voir le replay
Sartorius : Intégrité des données et niveau de connectivité augmentée pour un laboratoire moderne
Sartorius vous aide à améliorer l’intégrité de vos données et la connectivité.
Voir le replay
Thermo Scientific : Le complexe Burkholderia cepacia en toute simplicité
Cette conférence s’intéresse aux nouvelles directives et à la manière dont Thermofisher Scientific simplifie les défis liés à ce complexe.
Voir le replay
MP Biomedicals : Test sérologique rapide de la COVID-19
MP Biomedicals vous accompagne avec des solutions COVID-19.
Voir le replay
Eppendorf : Envie d’un défi ? Pipetage de liquides délicats
Manipulation réussie de liquides délicats. Instructions de base, techniques et astuces.
Voir le replay
Eppendorf : Comment les conseils sur les tubes, les plaques et les pipettes peuvent-ils influer sur vos expériences ?
Que sont les “substances lixiviables” ? Comment les substances lixiviables peuvent-elles impacter votre santé ? Pourquoi les fabricants utilisent-ils des additifs ?
Voir le replay
Eppendorf: Votre échantillon a de l’importance !
Savez-vous où se trouvent tous vos échantillons ? Pouvez-vous trouver les protocoles que vous utilisiez il y a 4 ans ?
Voir le replay
IBA Lifesciences: Étudier les interactions protéine-protéine
Découvrez les avantages de la technologie Strep-tag™ pour des résultats fiables.
Voir le replay
Découvrez le pouvoir Ultra : Conseils, astuces et avantages des dispositifs de préparation des échantillons de protéines
Démonstration en direct : Merck vous présente l'Amicon Ultra - la référence en matière de concentration des protéines.
Voir le replay
IBA: Purification de protéines évolutive : Rapide et facile
Les billes magnétiques d'IBA Life Science pour la purification des protéines, quelle que soit la taille de l'échantillon.
Voir le replay